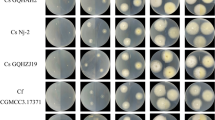

Abstract
The fungus Ramularia collo-cygni is the causal agent of the Ramularia leaf spot (RLS) disease of barley (Hordeum vulgare). Despite having been described over 100 years ago, our knowledge of the life cycle and epidemic development of R. collo-cygni is limited. To learn more about its epidemiology, inoculation techniques are among the major research needs since standardised inoculation procedures must be available to mimic natural infection of the pathogen under controlled conditions. The present study was conducted to obtain an insight into various factors affecting the growth and sporulation of R. collo-cygni in axenic culture. The fungus was cultured on four different media and subjected to two light regimens to determine conditions favourable for its growth and sporulation. We showed that conidial production can be enhanced by growing R. collo-cygni on barley straw agar, a medium that mimics the plant host, under white light, or on quarter-strength potato dextrose agar supplemented with V8 juice agar under ultraviolet-C light, depending on the fungal isolate. To verify the infection potential of the spores produced in axenic culture, an inoculation trial was performed. R. collo-cygni spore-inoculated barley plants accumulated fungal biomass, demonstrating successful infection.
Similar content being viewed by others
Avoid common mistakes on your manuscript.
Introduction
The ascomycete fungus Ramularia collo-cygni is the causal organism of Ramularia leaf spot (RLS) on barley (Hordeum vulgare L.). RLS is a disease characterised by small necrotic lesions, usually with a yellow halo (Salamati and Reitan 2006). Although R. collo-cygni was first described in 1893 (Cavara 1893), it was not until the late 1980s that the widespread distribution of the pathogen was reported in several countries in Europe, as well as in New Zealand, Argentina, and Uruguay (Harvey 2002; Sachs 2002; Walters et al. 2008). With barley production being the fourth highest of all cereals worldwide (Akar et al. 2004), the RLS pathogen has increasingly captured the attention of the scientific community (Havis et al. 2015). RLS is estimated to cause losses of up to 25% (occasionally up to 70%) of the crop yield potential through a significant decrease in kernel size and quality (Greif 2002; Harvey 2002). R. collo-cygni has also been isolated from maize (Stabentheiner et al. 2009), oat, wheat (Huss et al. 2005), and a number of non-cultivated grasses such as Agropyron repens and Lolium perenne (Peter Frei, Agroscope Changin, Switzerland, pers. comm.), suggesting a broader host range. However, RLS epidemics are rarely reported for crops other than barley (Havis et al. 2015; Huss et al. 2005). So far, it is not known whether isolates of R. collo-cygni are generally able to infect a wide range of host species or whether adaptation or even specialisation on certain hosts (e.g. barley) occurs within local populations.
The establishment of molecular-based tools has enabled the detection of R. collo-cygni throughout all the growth stages of the barley host plant (Havis et al. 2015). However, RLS is a disease that occurs late in the season. It is mainly after flowering that symptoms can be observed (Havis et al. 2015), suggesting that R. collo-cygni has a long latent period before harming the plant (Havis et al. 2014; Newton et al. 2010; Salamati and Reitan 2006). The mechanisms that trigger the fungus to switch from an endophytic phase to a parasitic one are not known. As a result, the epidemiology of this pathogen remains poorly understood (Havis et al. 2006; Walters et al. 2008).
To learn more about the epidemiology and biology of this pathogen, standardised experimental methods must be available. These methods enable the assessment of the pathogen’s different characteristics (Leiva-Mora et al. 2008). They also ensure reproducibility, providing consistent results that can be compared among different laboratories (Chen and Wang 2005). Consequently, research on inoculation methods is a priority to mimic natural infection of the pathogen under controlled conditions (Leiva-Mora et al. 2008). Additionally to its endophytic lifestyle and long latency, a major difficulty in the identification of R. collo-cygni is the confusion of the symptoms and the necrotic spots caused by abiotic stresses (physiological leaf spots, PLS) (Wu and von Tiedemann 2002). To reliably recognise and quantify R. collo-cygni DNA, a real-time quantitative polymerase chain reaction (RTqPCR) was developed by Taylor et al. (2010). They also established a correlation between the pathogen DNA quantity and disease symptoms. RTqPCR enabled us to quantitatively diagnose R. collo-cygni and monitor its development throughout the barley growing season. One other constraint to studying R. collo-cygni is the lack of reliable methods for producing quantifiable inoculum. R. collo-cygni shows little reproducible in vitro growth and sporulation (Frei and Gindrat 2000; Sachs 2002). Information about the nutritional requirements and environmental factors necessary for conidial production, their release, and conidial germination potential is lacking, thus hampering progress in studying and managing RLS.
The present study was conducted to provide greater insight into the factors affecting the in vitro sporulation of R. collo-cygni. The fungus was cultured on four media and subjected to two light conditions to determine conditions favourable for sporulation. The quality of spores generated axenically was validated by an inoculation trial to verify the infection potential of the spores produced in culture.
Material and method
Fungal isolates and culture maintenance
The three isolates of R. collo-cygni used were originally obtained from leaf material in our laboratory: Q2-3 (from spring barley ‘Quench’, leaf collected in Bavaria, Germany), Urug.2 (from spring barley, leaf collected in Uruguay), and Asano 1 (from winter wheat ‘JB Asano’, leaf collected in Bavaria, Germany). All isolates were stored at 4 °C in screw-cap test tubes that contained sterilised one-quarter-strength potato dextrose broth (Carl Roth GmbH + Co. KG, Karlsruhe, Germany). Mycelium of each isolate was transferred to 90-mm-diameter plastic petri dishes containing one-quarter-strength potato dextrose agar (¼PDA) (Carl Roth GmbH + Co. KG). The isolates were then incubated for 7 days in the dark at room temperature.
Culture media and incubation conditions
Two standard laboratory media were used: ¼PDA and V8 agar (150 mL Granini vegetable mixture juice, 3 g CaCO3, 15 g agar, adjusted to 1000 mL final volume). A medium involving overlapping agar wedges (¼PDA_V8) (Raymond et al. 1985) was also used. As described by Raymond et al. (1985), sterile molten ¼PDA was poured into slanted 90-mm-diameter plastic petri dishes to form a 70-mm-long agar wedge tapering from a thickness of 0–8 mm. After the agar had solidified, petri dishes were laid flat and 5–7 mL of molten V8 agar was added to the thin edge of the wedge. Another medium, the ‘barley straw agar’ (BSAgar), a modified version of the straw bran agar (Frei and Gindro 2015), was evaluated for supporting sporulation. Ground barley straw (40 g) and 20 g of agar were used per 1000 mL final volume.
All the media were sterilised by autoclaving at 121 °C for 20 min. Each sterilised medium was supplemented with 1 mL of 50 mg ml−1 streptomycin and 1 mL of 25 mg mL−1 aureomycin, poured in 90-mm-diameter plastic petri dishes and allowed to solidify at room temperature under sterile conditions.
A mycelial plug (5 mm diameter) taken from a 7-day-old ¼PDA culture of R. collo-cygni grown in the dark was placed in the centre of petri dishes, containing different agar media, except for the ¼PDA_V8 medium. In case of the latter, the mycelial plug was placed on the outer edge of the ¼PDA portion of the plate. All the petri dishes were sealed with parafilm.
Cultures were incubated for 21 days at 16 °C and 50% humidity under a 12-h/12-h light/dark cycle (Frei et al. 2007). Cultures were incubated under two light conditions to determine whether light affects sporulation. We used either white light (WL) (FSL T8 38 W/765, Philips Lighting GmbH, Hamburg, Germany) or short-wavelength ultraviolet (UVC) radiation (LT36/UVC, NARVA Lichtquellen GmbH + Co. KG, Brand-Erbisdorf, Germany).
Four replicate petri dishes were used for each isolate × medium × light treatment. The experiment was repeated three times.
Collection of conidia
Conidial production was evaluated after 21 days of incubation. From each of the different culture media, conidia were harvested by adding 5 mL of sterile distilled water to each petri dish and dislodging the conidia with a stainless steel spatula; the spore suspension was then transferred to a 2-mL Eppendorf tube (Raymond et al. 1985). An aliquot (15 µL) of each suspension was mounted on a hemocytometer (Thoma cell counting chamber) to determine the conidial concentration under a standard bright-field microscope.
Inoculation trial
Plant materials
The infection potential of in vitro-produced spores was investigated using barley ‘Golden Promise’. Five seeds per pot (48 cm3), with a total of 24 pots (12 replicates per treatment), were sown in ED73 substrate (CL ED73, Einheitserde Werkverband e.V., Sinntal-Altengronau, Germany). Plants were incubated in a climate chamber with 16-h/8-h light/dark cycle (150 µmol s−1 m−2 light intensity, 18 °C, 65% relative humidity) for 4 weeks (Makepeace et al. 2008).
Inoculum production
Isolate Q2-3 was used for the production of the inoculum. One mycelium plug was placed in the centre of each of the 12 petri dishes containing BSAgar and incubated for 21 days at 16 °C and 50% humidity under a 12-h/12-h WL/dark cycle (FSL T8 38 W/765).
A spore suspension (2 L) at 2 × 104 spores mL−1 was prepared using sterile distilled water to adjust to the desired concentration.
Plant inoculation
Four-week-old barley plants ‘Golden Promise’ were transferred to a greenhouse. The plants in 12 pots were inoculated by spraying with the prepared inoculum containing axenically produced conidia suspended in water, while the other 12 pots were replicates of the control, which were sprayed with water. Both the inoculum and water solutions were applied using a pressure sprayer (Gardena Drucksprüher 1.25 l 00814-20, Gardena Manufacturing GmbH, Ulm, Germany), until run-off (Makepeace et al. 2008). Leaves (20 randomly picked from each condition) and pictures were taken every week for 5 weeks (from growth stage GS20-26 until GS45-50).
Isolation of genomic DNA from inoculated barley
Isolation of R. collo-cygni DNA was carried out following the protocol of Moreno et al. (2008) with minor modifications. Genomic DNA was extracted by grinding the plant material to a fine powder in liquid nitrogen. Finely ground tissue (2 g) was mixed vigorously with 1 mL of pre-heated extraction buffer [1 volume TEN (400 mM TrisHCl, 50 mM EDTA, 500 mM NaCl, pH 8), 1 volume 2% (w/v) sodium dodecyl sulphate, 4.2% polyvinylpyrrolidone, 0.19% phenanthroline, and 0.1% β-mercaptoethanol]. After incubation at 65 °C for 20 min, the sample was centrifuged at 10,000 × g at room temperature. An aliquot (1 mL) of the supernatant was transferred to a new reaction tube. The solution was then mixed vigorously with 1 volume of sodium acetate (1 mL) and placed for 20 min on ice. After centrifugation for 15 min (4 °C), the supernatant was poured into a new reaction tube. One volume of cold isopropanol was then added. After 15 min of incubation at room temperature, the sample was centrifuged for 15 min (at room temperature), the supernatant was discarded, and the pellet was washed with 400 µL of 70% (v/v) ethanol. The sample was then vacuum-dried and resuspended in 200 µL of sterile distilled water.
R. collo-cygni DNA quantification
Quantification of R. collo-cygni DNA in genomic DNA extracts from inoculated and non-inoculated leaves was performed following a Taq-Man qPCR protocol (Taylor et al. 2010). Briefly, 1 × iQ Supermix (Bio-Rad, Hercules, CA, USA), 400 nmol forward and reverse primers (RamF6/RamR6 (Taylor et al. 2010)), 150 nmol Ramularia probe (FAM; Ram6 (Taylor et al. 2010)), 5 μL DNA template (20 ng μl−1), and PCR-grade water were mixed together to make the reaction mixture (25 µL final volume). PCR amplification was performed using an MX3000P Cycler (Stratagene, La Jolla, CA, USA): 10 min for a hot start at 95 °C; 50 cycles of denaturation at 95 °C for 20 s, annealing at 55 °C for 20 s and extension at 72 °C for 20 s; and an additional extension step at 95 °C for 1 min. Analysis of the RTqPCR products was carried out with the MxPRO QPCR software (Stratagene, La Jolla, CA, USA).
Statistical analysis
Data processing was carried out using Microsoft Office Excel 2013. Summary statistics were expressed as mean + SD. One-way analysis of variance (ANOVA) was used to analyse the data, with the Tukey B test used to identify statistically significant differences between individual treatments in multiple pairwise comparisons in post hoc tests (p ≤ 0.05) using the IBM SPSS statistical software (version 21) (IBM, Armonk, NY, USA).
Results
Effects of different media and light sources on in vitro spore production
To evaluate the effect of different media and light conditions, R. collo-cygni was cultured on four media (¼PDA, V8, BSAgar, and ¼PDA_V8) and subjected to two light sources (WL and UVC).
With more than 25 × 104 spores mL−1, spore production was the highest on BSAgar, followed closely by ¼PDA_V8 (16.8 × 104 spores.mL−1) (Fig. 1a). The number of spores formed on ¼PDA and V8 was extremely low (Fig. 1a). Spore production was significantly higher on BSAgar and ¼PDA_V8 than on the other two media, with cultures on BSAgar producing significantly more spores than did cultures on ¼PDA_V8 medium.
Effect of different media (a) and light regimen (b) on spores production of Ramularia collo-cygni. Vertical bars represent standard error of mean. Statistically significant differences according to Tukey B test (p ≤ 0.05) in spore number are marked by different letters according to analyses of variance results. 1/4 PDA = one fourth strength potato dextrose agar, V8 = V8 juice agar, 1/4 PDA_V8 = overlapping of ¼ PDA and V8 agar wedges, BSAgar = barley straw agar, WL = white light, UVC = short-wavelength ultraviolet
Spore production under UVC light (12.2 × 104 spores.mL−1) was slightly but not significantly (p > 0.05) higher than that under WL light (11.7 × 104 spores mL−1) (Fig. 1b).
Interactions among media and light
We had observed that the highest number of conidia [significantly higher (p ≤ 0.05) than that produced by the other treatments] was produced by cultures growing on BSAgar. However, light also affected R. collo-cygni spore production, the effect depending on which medium the fungus was cultured on (Fig. 2). When the isolate was cultured under WL, BSAgar appeared to be the most favourable environment for spore production (39.7 × 104 spores mL−1) compared with ¼PDA_V8 (3.4 × 104 spores mL−1) (p < 0.05). By contrast, when grown under UVC light, sporulation was the greatest on ¼PDA_V8 (30.2 × 104 spores mL−1) compared with that on BSAgar (12.3 × 104 spores mL−1). Neither ¼PDA nor V8 media supported high sporulation rates under either light condition.
Interactions among media and light regarding spores production of Ramularia collo-cygni. Vertical bars represent standard error of mean. Statistically significant differences according to Tukey B test (p ≤ 0.05) in spores number are marked by different letters according to analyses of variance results. 1/4 PDA = one fourth strength potato dextrose agar, V8 = V8 juice agar, 1/4 PDA_V8 = overlapping of ¼ PDA and V8 agar wedges, BSAgar = barley straw agar, WL = white light, UVC = short-wavelength ultraviolet
Genotypic effect of different isolates
For this study, we tested the response of the different isolates to determine whether they display the same potential for sporulation under similar conditions. When spore production of each isolate was individually checked, we observed that they did not exhibit the same behaviour (Fig. 3). The isolate Q2-3 seemed to be the best performing one with regard to sporulation. Under most of the conditions, with a particular preference for the BSAgar-WL conditions (112.8 × 104 spores mL−1), it produced more conidia than the other isolates. The isolate Asano preferred the medium ¼PDA_V8 under UVC light for sporulation (60.0 × 104 spores mL−1). The isolate Urug.2 produced very few spores under all tested conditions.
Sporulation of different isolates under different growth conditions. Vertical bars represent standard error of mean. Statistically significant differences according to Tukey B test (p ≤ 0.05) in spore number are marked by different letters according to analyses of variance results. 1/4 PDA_V8 = overlapping of ¼ PDA and V8 agar wedges, BSAgar = barley straw agar, WL = white light, UVC = short-wavelength ultraviolet. Urug.2, Q2-3 and Asano are three different R. collo-cygni isolates
Inoculation trial
An inoculation trial was designed to test the infection potential of the spores produced in axenic culture (BSAgar, WL regimen). Barley plants were sprayed with either a spore suspension (‘inoculated’) or water (‘control’). The infection was then monitored for 32 days (Fig. 4), and R. collo-cygni DNA concentration in inoculated and control leaves was quantified (Fig. 5). We observed the appearance of the first necrotic symptoms on the inoculated plants 14 days post-inoculation (dpi). Symptoms were consistent with those usually found under field conditions. Moreover, the density of necrotic spots increased over time (Fig. 4). Additionally, the R. collo-cygni DNA concentration was significantly higher (p ≤ 0.05) in the 14-dpi inoculated leaves (12.3 pg R. collo-cygni DNA/ng total DNA) than in the 14-dpi control leaves (3.16 pg R. collo-cygni DNA/ng total DNA) (Fig. 5). Similarly, R. collo-cygni DNA concentration significantly increased from the 0-dpi inoculated leaves (4.93 pg R. collo-cygni DNA/ng total DNA) to the 14-dpi inoculated leaves. At later time points, there was no further increase in R. collo-cygni DNA levels, but the inoculation success became visibly evident through symptom formation (Fig. 4).
Ramularia collo-cygni quantification on barley leaves after inoculation. R. collo-cygni DNA amounts were defined via quantitative polymerase chain reaction and are indicated in picograms of R. collo-cygni DNA per nanograms of total DNA. Dpi = days post-inoculation. Errors bars show standard deviation. Statistical differences between 0dpi inoculated and 14dpi inoculated are indicated by letters according to Tukey B test (p ≤ 0.05). Statistical differences between the mock and inoculated conditions for each time point are indicated by *for p ≤ 0,05 and **for p ≤ 0,01 according to ANOVA test
These results demonstrated that the in vitro-produced spores were viable and virulent on barley under the experimental design.
Discussion
Manipulation of the culture medium composition and environmental growth conditions is a simple but effective way of influencing the growth, development reproduction, behaviour, and metabolism of fungal isolates (Ajdari et al. 2011). To increase the value of in vitro studies of plant–pathogen interaction, there is a need for better understanding of the factors that affect vegetative growth and sporulation (Soltani et al. 2014). In this study, four media and two light conditions were tested to identify conditions favourable for the sporulation of R. collo-cygni isolates. Results indicated that the sporulation of these isolates was influenced by the composition of the culture medium and light conditions under which the fungus was cultured. We showed that conidial production can be enhanced by growing R. collo-cygni on BSAgar under WL or on ¼PDA_V8 under UVC light regimen, depending on the isolate. A previous study had shown that transition of Pyrenophora tritici-repentis from a nutritionally poor medium to a richer medium could induce sporulation (Raymond et al. 1985), a finding which may mirror what happened when R. collo-cygni was transferred to ¼PDA_V8. V8 juice agar represents a richer medium than ¼PDA. Additionally, exposure to stress-inducing UV light has already been reported to induce sporulation of other fungi (McCallan and Chan 1944; Ramsey and Bailey 1930).
One recent study specifically addressed the sporulation of R. collo-cygni under in vitro laboratory conditions (Frei and Gindro 2015). These authors observed sporulation on a straw bran agar similar to our medium BSAgar. Together, these two reports support the hypothesis that straw-derived molecules can trigger sporulation of R. collo-cygni in otherwise sterile axenic culture. Our BSAgar was designed to mimic the plant host. Cercospora kikuchii, closely related to R. collo-cygni (Crous et al. 2000), sporulates most strongly under axenic culture conditions that closely resemble those in nature (Vathakos and Walters 1979). As a necrotrophic soybean pathogen, the conidia production of C. kikuchii is most profusely induced on medium prepared from senescent soybean plants. Under field conditions, R. collo-cygni sporulates heavily during leaf senescence. Potentially, amending the medium with barley straw mimicked its natural growth conditions. However, only one isolate sporulated profusely on BSAgar. Fungi show diversity among isolates; for example, several Botrytis cinerea field isolates exhibited different requirements for sporulation (Cotoras et al. 2009).
Under natural conditions, light and nutrients are factors that greatly affect the development and fitness of pathogenic fungi (Hosseyni-Moghaddam and Soltani 2013). In their study, the authors demonstrated the induction of increased sporulation by Magnaporthe oryzae, a rice pathogen, by optimising the composition of the culture medium. In the same manner as for R. collo-cygni, supplementation of the medium with host plant material, like polished rice, rice extract, or rice leaf segments, induced the production of a large number of conidia. Similar factors have been reported to affect sporulation for other species such as Alternaria species on potato (Van der Waals et al. 2001). Similar to R. collo-cygni, Alternaria solani sporulated in vitro only after being induced by altering the growth conditions. Several groups had focused their research on the induction of sporulation by this fungus (Bashi and Rotem 1976; Lukens 1963, 1965; McCallan and Chan 1944). Factors such as wounding, temperature, and light affected sporulation. Our findings support these facts. Culture parameters, from light conditions to nutritional requirements and isolate diversity, affected R. collo-cygni sporulation in vitro.
In our study, the in vitro-produced spores were viable and virulent on barley. Symptoms induced in the inoculation trial are consistent with those previously described (Salamati and Reitan 2006) and which are usually found in the field (Havis et al. 2015). Since the RLS symptoms are easily confused with the PLS symptoms, RTqPCR was used to reliably identify and quantitatively detect R. collo-cygni in infected barley. This method allowed us to follow the fungus from the infection through the latent endophytic state to symptom development during our inoculation trial. The increase in R. collo-cygni DNA concentration in the leaves over time supports the model that inoculation with the axenically produced spores was successful. The inoculation procedure could be further optimised by modifying the plant material or testing different extracts and fractions. Nevertheless, with our ability now to produce quantifiable inoculum, we have the appropriate tool to investigate and optimise it further.
Findings of the present study will be helpful in the culture of R. collo-cygni. The production of a quantifiable source of inoculum under controlled conditions can significantly help standardising testing procedures, especially with respect to phenotyping. From fungicide-sensitivity tests to infection assays, including gene expression analysis or cultivar resistance screening, there are various uses for standardised spores produced in vitro (Allioui et al. 2016; Hayes et al. 2016; Heick et al. 2017; Kamoun et al. 1998; Koudela and Novotný 2016; Matsumura et al. 2003; Vasileva et al. 2016).
The complex life cycle of R. collo-cygni still needs to be investigated to fully understand it. Seed-borne inoculum seems to be important for global geographical dispersal of this pathogen (Havis et al. 2014, 2006; Stam et al. 2017), whereas airborne inoculum can play an important role for a fast and efficient spread of the disease within a growing season or between winter and spring crops (Havis et al. 2015; Sachs 2006; Zamani-Noor 2011). Being able to produce spores under controlled condition allows us to further investigate the relevance of the different sources of R. collo-cygni infection. It also provides us with a valuable tool with which to achieve a better understanding of R. collo-cygni biology and for optimising (Havis et al. 2015; Sachs 2006; Zamani-Noor 2011) disease management.
Taken all together, this study offers further improvement of protocols that support in vitro sporulation of R. collo-cygni and shows that it is possible to cause RLS-like infection of barley by inoculation using the axenic spore material produced.
Data availability
The datasets generated and analysed during the current study are available from the corresponding author on reasonable request.
References
Ajdari Z, Ebrahimpour A, Abdul Manan M, Hamid M, Mohamad R, Ariff AB (2011) Nutritional requirements for the improvement of growth and sporulation of several strains of Monascus purpureus on solid state cultivation. J Biomed Biotechnol 2011:487329. https://doi.org/10.1155/2011/487329
Akar T, Avci M, Dusunceli F (2004) Barley: post harvest operations. The Central Research Institute for Field Crops, Food and Agriculture Organization (FAO) of the United Nations, Ankara
Allioui N, Siah A, Brinis L, Reignault P, Halama P (2016) Identification of QoI fungicide-resistant genotypes of the wheat pathogen Zymoseptoria tritici in Algeria. Phytopathol Mediterr 55:89
Bashi E, Rotem J (1976) Induction of sporulation of Alternaria porri f. sp. solani in vivo. Physiol Plant Pathol 8:83–90
Cavara F (1893) Über einige parasitische Pilze auf dem Getreide. Z Pflanzenkrankh 3:16–26
Chen Y, Wang D (2005) Two convenient methods to evaluate soybean for resistance to Sclerotinia sclerotiorum. Plant Dis 89:1268–1272
Cotoras M, García C, Mendoza L (2009) Botrytis cinerea isolates collected from grapes present different requirements for conidia germination. Mycologia 101:287–295. https://doi.org/10.3852/08-012
Crous PW, Aptroot A, Kang J-C, Braun U, Wingfield MJ (2000) The genus Mycospharella and its anamorphs. Stud Mycol 45:107–122
Frei P, Gindrat D (2000) Le champignon Ramularia collo-cygni provoque une forme de grillures sur les feuilles d’orge d’automne et de graminées adventices. REVUE SUISSE D AGRICULTURE 6:229–234
Frei P, Gindro K (2015) Ramularia collo-cygni–un nouveau champignon pathogène de l’orge. Rech agron suisse 6:210–217
Frei P, Gindro K, Richter H, Schürch S (2007) Direct-PCR detection and epidemiology of Ramularia collo-cygni associated with barley necrotic leaf spots. J Phytopathol 155:281–288
Greif P (2002) Importance of Ramularia collo-cygni for barley growers and breeders. In: Proceedings of the 2nd international workshop on barley leaf blights, pp 7–11
Harvey I (2002) Epidemiology and control of leaf and awn spot of barley caused by Ramularia collo-cygni. N Z Plant Prot 55:331–335
Havis N, Pastok M, Pyzalski S, Oxley S, Heilbronn T (2006) Investigating the life cycle of Ramularia collo-cygni. In: Proceedings crop protection in Northern Britain, pp 219–224
Havis N, Nyman M, Oxley S (2014) Evidence for seed transmission and symptomless growth of Ramularia collo-cygni in barley (Hordeum vulgare). Plant Pathol 63:929–936
Havis ND et al (2015) Ramularia collo-cygni—an emerging pathogen of barley crops. Phytopathology 105:895–904. https://doi.org/10.1094/phyto-11-14-0337-fi
Hayes LE, Sackett KE, Anderson NP, Flowers MD, Mundt CC (2016) Evidence of selection for fungicide resistance in Zymoseptoria tritici populations on wheat in western Oregon. Plant Dis 100:483–489
Heick TM, Justesen AF, Jørgensen LN (2017) Resistance of wheat pathogen Zymoseptoria tritici to DMI and QoI fungicides in the Nordic-Baltic region—a status. Eur J Plant Pathol. https://doi.org/10.1007/s10658-017-1216-7
Hosseyni-Moghaddam M, Soltani J (2013) An investigation on the effects of photoperiod, aging and culture media on vegetative growth and sporulation of rice blast pathogen Pyricularia oryzae. Prog Biol Sci 3:135–143
Huss H, Liebermann B, Miethbauer S (2005) Eine erstzunehmende Krankheit auch bei Hafer und Weizen: Weitere Ausbreitung der Sprenkelkrankheit. Der Pflanzenartz 9–10:8–10
Kamoun S, van West P, Vleeshouwers VG, de Groot KE, Govers F (1998) Resistance of Nicotiana benthamiana to Phytophthora infestans is mediated by the recognition of the elicitor protein INF1. Plant Cell 10:1413–1425
Koudela M, Novotný Č (2016) Influence of cultivars and seed thermal treatment on the development of fungal pathogens in carrot and onion plants. Acta Universitatis Agriculturae et Silviculturae Mendelianae Brunensis 64:1181–1189
Leiva-Mora M, Alvarado-Capó Y, Acosta-Suárez M, Cruz-Martín M, Sánchez C, Roque-Morales B (2008) Enhanced sporulation, morphological and pathogenic characterization of Mycosphaerella fijiensis, causal agent of Musa Black leaf streak. Centro Agrícola 35:33–39
Lukens R (1963) Photo-inhibition of sporulation in Alternaria solani. Am J Bot 50:720–724
Lukens R (1965) Reversal by red light of blue light inhibition of sporulation in Alternaria solani, vol 55. American Phytopathological Society, St Paul
Makepeace JC, Havis ND, Burke JI, Oxley SJP, Brown JKM (2008) A method of inoculating barley seedlings with Ramularia collo-cygni. Plant Pathol 57:991–999. https://doi.org/10.1111/j.1365-3059.2008.01892.x
Matsumura H et al (2003) Gene expression analysis of plant host–pathogen interactions by SuperSAGE. Proc Natl Acad Sci 100:15718–15723. https://doi.org/10.1073/pnas.2536670100
McCallan S, Chan SY (1944) Inducing sporulation of Alternaria solani in culture. Contrib Boyce Thompson Inst 13:323–336
Moreno M, Stenglein S, Balatti P, Perelló A (2008) Pathogenic and molecular variability among isolates of Pyrenophora tritici-repentis, causal agent of tan spot of wheat in Argentina. Eur J Plant Pathol 122:239–252
Newton AC, Fitt BD, Atkins SD, Walters DR, Daniell TJ (2010) Pathogenesis, parasitism and mutualism in the trophic space of microbe—plant interactions. Trends Microbiol 18:365–373
Ramsey GB, Bailey AA (1930) Effects of ultra-violet radiation upon sporulation in macrosporium and fusarium. Bot Gaz 89:113–136. https://doi.org/10.1086/334040
Raymond P, Bockus W, Norman B (1985) Tan spot of winter wheat: procedures to determine host response. Phytopathology 75:686–690
Sachs E (2002) A ‘new’ leaf spot disease of barley caused by Ramularia collo-cygni: description, diagnosis and comparison with other leaf spots. In: Meeting the challenges of barley blights. Proceedings of the second international workshop on barley leaf blights, pp 365–369
Sachs E (2006) The history of research into Ramularia leaf spot on barley. Nachrichtenblatt des Deutschen Pflanzenschutzdienstes 58:186
Salamati S, Reitan L (2006) Ramularia collo-cygni on spring barley, an overview of its biology and epidemiology. In: Proceedings 1st European Ramularia workshop, pp 19–35
Soltani J, Haghighi MY-P, Nazeri S (2014) Light, temperature, and aging dependent vegetative growth and sporulation of Colletotrichum gloeosporioides on different culture media. J Med Plants Res 8:208–216
Stabentheiner E, Minihofer T, Huss H (2009) Infection of barley by Ramularia collo-cygni: scanning electron microscopic investigations. Mycopathologia 168:135–143. https://doi.org/10.1007/s11046-009-9206-8
Stam R, Sghyer H, Münsterkötter M, Pophaly S, Tellier A, Güldener U, Hückelhoven R, Hess M (2017) The evolutionary history of the current global Ramularia collo-cygni epidemic. bioRxiv. https://doi.org/10.1101/215418
Taylor JM, Paterson LJ, Havis ND (2010) A quantitative real-time PCR assay for the detection of Ramularia collo-cygni from barley (Hordeum vulgare). Lett Appl Microbiol 50:493–499. https://doi.org/10.1111/j.1472-765X.2010.02826.x
Van der Waals J, Korsten L, Aveling T (2001) A review of early blight of potato. Afr Plant Prot 7:91–102
Vasileva K, Malchev S, Zhivondov A (2016) Sensitivity of promising cherry hybrids and new cultivars to economically important fungal diseases. Agric Sci Technol 8:197–200
Vathakos M, Walters H (1979) Production of conidia by Cercospora kikuchii in culture. Phytopathology 69:832–833
Walters DR, Havis ND, Oxley SJP (2008) Ramularia collo-cygni: the biology of an emerging pathogen of barley. FEMS Microbiol Lett 279:1–7. https://doi.org/10.1111/j.1574-6968.2007.00986.x
Wu Y-X, von Tiedemann A (2002) Evidence for oxidative stress involved in physiological leaf spot formation in winter and spring barley. Phytopathology 92:145–155
Zamani-Noor N (2011) Studies on Ramularia Leaf Spots on Barley-Resistance Phenotyping, Epidemiology and Pathogenicity. Doctoral dissertation, Niedersächsische Staats-und Universitätsbibliothek Göttingen. http://hdl.handle.net/11858/00-1735-0000-0001-BC13-F. Accessed 22 Apr 2019
Acknowledgments
We thank Carolin Hutter and Regina Dittebrand for their technical assistance. Special thanks goes to Prof. Dr. Ralph Hückelhoven for his critical reading of the manuscript, and to the Bavarian State Ministry of Food, Agriculture and Forestry for financial support (Project KL/12/07 and KL/08/07). We also thank Stephan Weigand from the Bavarian State Research Center for Agriculture for his fruitful discussion.
Author information
Authors and Affiliations
Contributions
HS and MH conceived the experiments. HS conducted the experiments and analysed the results. All authors reviewed the manuscript.
Corresponding authors
Ethics declarations
Conflict of interest
The authors declare that they have no conflict of interest.
Ethical statement
This article does not contain any studies with human or animal subjects.
Additional information
Publisher's Note
Springer Nature remains neutral with regard to jurisdictional claims in published maps and institutional affiliations.
Rights and permissions
About this article
Cite this article
Sghyer, H., Hess, M. Culture conditions influence conidial production by the barley pathogen Ramularia collo-cygni. J Plant Dis Prot 126, 319–327 (2019). https://doi.org/10.1007/s41348-019-00226-8
Received:
Accepted:
Published:
Issue Date:
DOI: https://doi.org/10.1007/s41348-019-00226-8